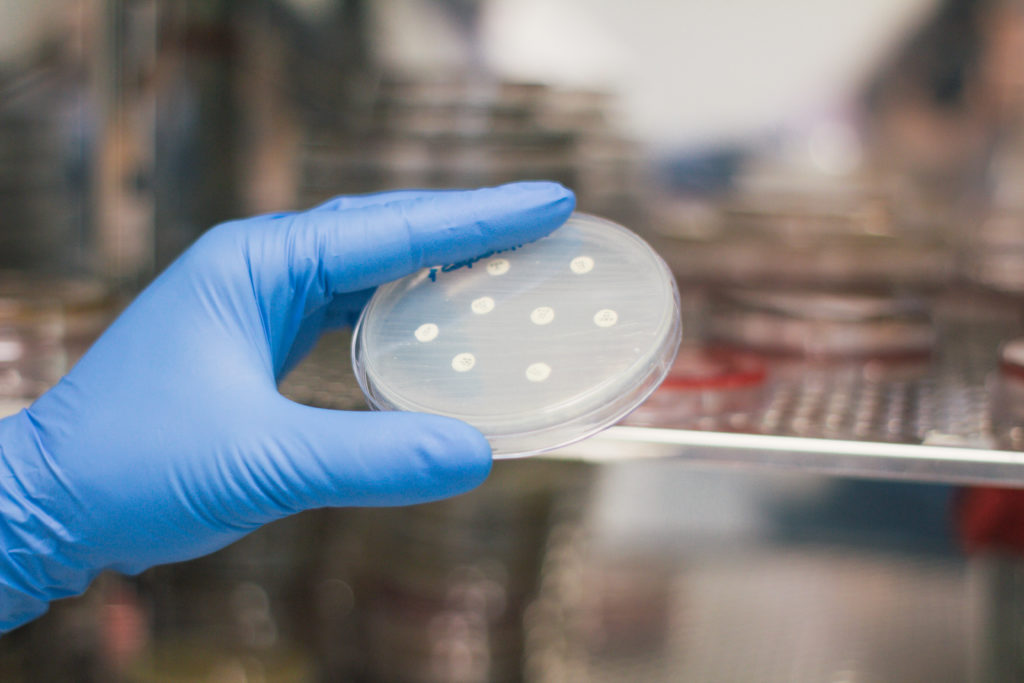

Larrasa Animal Genetics S.l.
Direccion: Pol. Ind. Albuera, 17
+34 924480190
0 comentarios
Larrasa Animal Genetics S.l.
Larrasa Animal Genetics S.l. centra su actividad en Consultas y clínicas veterinarias. Larrasa Animal Genetics S.l. es una compañía que realiza su actividad desde Poligono industrial de la albuera, 17 en La albuera, Badajoz. El código del CNAE con el que se encuentra relacionada es 7500 - Actividades veterinarias. Fue creada hace 4 Años, 8 Meses y 5 Días, el 15/12/2016. Su volumen de ventas se sitúa entre Mayor de 30 millones €. El capital social de la empresa es De 0 a 3.100 €.
- Categoria: Actividades Profesionales, Cientificas Y Tecnicas
- Subcategoria: Actividades Veterinarias
Rede Social
Comentarios
Añadir Comentario
Pol. Ind. Albuera, 17
La Albuera
Badajoz - Extremadura
La Albuera
Badajoz - Extremadura